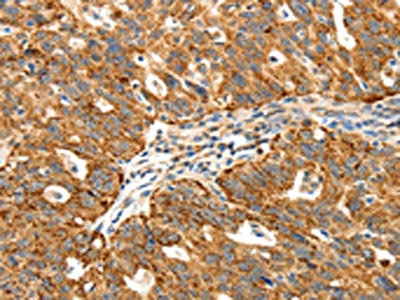

SSTR1 Antibody
-
中文名稱:SSTR1兔多克隆抗體
-
貨號:CSB-PA075436
-
規格:¥1100
-
圖片:
-
The image on the left is immunohistochemistry of paraffin-embedded Human liver cancer tissue using CSB-PA075436(SSTR1 Antibody) at dilution 1/40, on the right is treated with synthetic peptide. (Original magnification: ×200)
-
The image on the left is immunohistochemistry of paraffin-embedded Human ovarian cancer tissue using CSB-PA075436(SSTR1 Antibody) at dilution 1/40, on the right is treated with synthetic peptide. (Original magnification: ×200)
-
Gel: 10%SDS-PAGE, Lysate: 60 μg, Lane 1-2: 293T cells, hela cells, Primary antibody: CSB-PA075436(SSTR1 Antibody) at dilution 1/500, Secondary antibody: Goat anti rabbit IgG at 1/8000 dilution, Exposure time: 30 seconds
-
-
其他:
產品詳情
-
Uniprot No.:
-
基因名:
-
別名:SSTR1; Somatostatin receptor type 1; SS-1-R; SS1-R; SS1R; SRIF-2
-
宿主:Rabbit
-
反應種屬:Human,Mouse,Rat
-
免疫原:Synthetic peptide of Human SSTR1
-
免疫原種屬:Homo sapiens (Human)
-
標記方式:Non-conjugated
-
抗體亞型:IgG
-
純化方式:Antigen affinity purification
-
濃度:It differs from different batches. Please contact us to confirm it.
-
保存緩沖液:-20°C, pH7.4 PBS, 0.05% NaN3, 40% Glycerol
-
產品提供形式:Liquid
-
應用范圍:ELISA,WB,IHC
-
推薦稀釋比:
Application Recommended Dilution ELISA 1:2000-1:5000 WB 1:500-1:2000 IHC 1:50-1:200 -
Protocols:
-
儲存條件:Upon receipt, store at -20°C or -80°C. Avoid repeated freeze.
-
貨期:Basically, we can dispatch the products out in 1-3 working days after receiving your orders. Delivery time maybe differs from different purchasing way or location, please kindly consult your local distributors for specific delivery time.
-
用途:For Research Use Only. Not for use in diagnostic or therapeutic procedures.
相關產品
靶點詳情
-
功能:Receptor for somatostatin with higher affinity for somatostatin-14 than -28. This receptor is coupled via pertussis toxin sensitive G proteins to inhibition of adenylyl cyclase. In addition it stimulates phosphotyrosine phosphatase and Na(+)/H(+) exchanger via pertussis toxin insensitive G proteins.
-
基因功能參考文獻:
- High SSTR1 expression is associated with hepatocellular and cholangiocellular carcinomas in tumor capillaries. PMID: 29282035
- Data showed that the distribution of somatostatin receptor (SSTR) subtypes among the 199 pancreatic neuroendocrine tumors (PNETs) was: SSTR2 (54.8%), SSTR1 (53.3%), SSTR4 (51.8%), SSTR5 (33.7%), and SSTR3 (28.6%). PMID: 26474434
- An immunohistochemical investigation of the expression of somatostatin receptor subtypes PMID: 25962406
- The UMB-7 may prove of great value in the identification of sst1-expressing tumors during routine histopathological examinations. This may open up new routes for diagnostic and therapeutic intervention. PMID: 23466804
- SSTR-PET showed high sensitivity for imaging bone, soft tissue and brain metastases, and particularly in combination with CT had a significant impact on clinical stage and patient management. PMID: 24742330
- SSTRs are overexpressed in primary pigmented nodular adrenocortical disease tissues in comparison with normal adrenal cortex PMID: 24512486
- Activated/phosphorylated pMAPK 44/42 was detected in 82% of medulloblastomas, all subtypes, and in 62.5% of primitive neuroectodermal tumors with coexpression of SSR1 in one third. PMID: 23455179
- Somatostatin receptor imaging (SRI) using SPECT or PET as a whole-body imaging technique has become a crucial part of the management of Neuroendocrine tumors PMID: 24106690
- Tumor cells in the tissue samples of the patients diagnosed with advanced-stage hepatocellular carcinoma expressed a high proportion of SSTR1 and SSTR5. PMID: 24634938
- Somatostatin receptor 1 is a novel methylated gene driven by EBV infection in gastric cancer cells and acts as a potential tumour suppressor. PMID: 23722468
- Data demonstrate that cells transfected with SSTR1 or SSTR1/5 negatively regulates EGF mediated effects attributed to the inhibition of EGFR phosphorylation. PMID: 21419811
- Data show that the mRNA levels of SSTR1, SSTR2, SSTR3, and SSTR5 were high in PET compared with AC, whereas the expression of SSTR4 was low in PET and AC. PMID: 20717067
- Studies show that this study may be the basis for further functional studies to evaluate the role of somatostatin receptors sst1 to sst5 in the diabetic state. PMID: 20182388
- Overexpressed in endomterium inendometriosis. PMID: 20739383
- The summarized expression pattern of SSTR in the investigated neuroendocrine tumors in our material was: SSTR 1> SSTR 5> SSTR 3> SSTR 2A> SSTR 2B. PMID: 20529830
- SSTR1 had higher expression in patients that had normalized GH and IGF-I. There was a positive correlation between the percentage of tumor reduction by octreotide-lar and SSTR1 expression. PMID: 19330452
- SSTR transcripts are expressed and functional in retroorbital fibroblasts. SSTR1 is expressed in Grave's disease and octreotide inhibits retroorbital cell growth, explaining the SRIH therapeutic effect. PMID: 11753241
- SSTRs 1-5 are heterogeneously expressed in gastroenteropancreatic endocrine tumors PMID: 12021920
- selective activation reduces cell growth and calcitonin secretion in a human medullary thyroid carcinoma cell line PMID: 12359227
- the expression of somatostatin (SS) and SS receptor (SSR) subtype 1 (sst1), sst2A, and sst3 in normal human thymic tissue PMID: 12376335
- somatostatin receptor transcripts were found in lymphocytes both from Graves' ophthalmopathy retroorbital tissues and blood samples, with levels of expression of SST1, -2, and -4 mRNA higher than those of the SST3 and -5 transcripts PMID: 12414882
- localization and expression in human prostatic tissue and prostate cancer cell lines PMID: 12474541
- SSTR1 selective activation inhibits hormone secretion and cell viability in GH- and PRL-secreting adenomas in. SRIF analogs with affinity for SSTR1 may be useful to control hormone hypersecretion and reduce neoplastic growth of pituitary adenomas. PMID: 12788890
- activation of hSSTR1 is not necessary for heterodimeric assembly PMID: 15247250
- transcriptional regulation of the human SST1 was analyzed in the present study PMID: 17533578
- Analysis of orbital tissues reveals upregulation of SSTR1 and -2 in a group of Graves' ophthalmopathy (GO)patients. Adipogenesis, a process occurring in GO orbits, provides one possible explanation for some of the observed increase. PMID: 17848636
- The most prominent candidates associated with aggressive prostate cancer were SSTR1 and genes related to proliferation, including TOP2A. PMID: 18347174
- the expression of SSTR-1 mRNA in human pancreatic cancer tissue specimens, and investigated the effect of SSTR-1 overexpression on cell proliferation, cell cycle, and tumor growth in a subcutaneous nude mouse model. PMID: 18823376
- Immunohistochemistry stufy of SSTR1 in prostate tissue from patients with bladder outlet obstruction showed that greatest proportion of basal cells showed a moderate intensity, strong immunoreactivity being observed only in 18.1% of cells. PMID: 18936524
- To the best of our knowledge, this is the first report describing crosstalk/interactions between SSTRs and ErbBs. PMID: 19070659
- Both SSTR1 and 2 mRNA levels in SCA were greater than Cushing disease, while SSTR1 mRNA levels, but not SSTR2, in silent corticotroph adenoma were also greater than non-functioning pituitary tumor. PMID: 19318729
顯示更多
收起更多
-
亞細胞定位:Cell membrane; Multi-pass membrane protein.
-
蛋白家族:G-protein coupled receptor 1 family
-
組織特異性:Fetal kidney, fetal liver, and adult pancreas, brain, lung, jejunum and stomach.
-
數據庫鏈接:
Most popular with customers
-
-
YWHAB Recombinant Monoclonal Antibody
Applications: ELISA, WB, IHC, IF, FC
Species Reactivity: Human, Mouse, Rat
-
Phospho-YAP1 (S127) Recombinant Monoclonal Antibody
Applications: ELISA, WB, IHC
Species Reactivity: Human
-
-
-
-
-